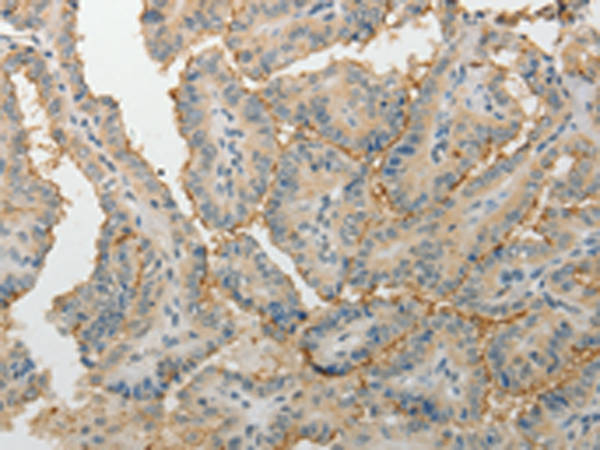

中文名稱: 兔抗MPZ多克隆抗體
英文名稱: Anti-MPZ rabbit polyclonal antibody
別 名: P0; CHM; DSS; MPP; CMT1; CMT1B; CMT2I; CMT2J; CMT4E; CMTDI3; CMTDID; HMSNIBw
抗 原: MPZ
儲 存: 冷凍(-20℃)
宿 主: Rabbit
相關(guān)類別: 一抗
反應(yīng)種屬: Human, Mouse, Rat
標(biāo) 記 物: Unconjugate
克隆類型: rabbit polyclonal
技術(shù)規(guī)格
|
Background: |
This gene encodes a major structural protein of peripheral myelin. Mutations in this gene result in the autosomal dominant form of Charcot-Marie-Tooth disease type 1 and other polyneuropathies. The myelin sheath is a multi-layered membrane, unique to the nervous system, that functions as an insulator to greatly increase the velocity of axonal impulse conduction. The P0 glycoprotein, absent in the central nervous system,[1] is a major component of the myelin sheath in peripheral nerves. It comprises a large extracellular N-terminal domain, a single transmembrane (TM) region, and a smaller positively charged intracellular domain. |
|
Applications: |
ELISA, IHC |
|
Name of antibody: |
MPZ |
|
Immunogen: |
Fusion protein of human MPZ |
|
Full name: |
myelin protein zero |
|
Synonyms: |
P0; CHM; DSS; MPP; CMT1; CMT1B; CMT2I; CMT2J; CMT4E; CMTDI3; CMTDID; HMSNIB |
|
SwissProt: |
P25189 |
|
ELISA Recommended dilution: |
1000-2000 |
|
IHC positive control: |
Human thyroid cancer |
|
IHC Recommend dilution: |
15-50 |
購物車
購物車 幫助
幫助
 021-54845833/15800441009
021-54845833/15800441009
